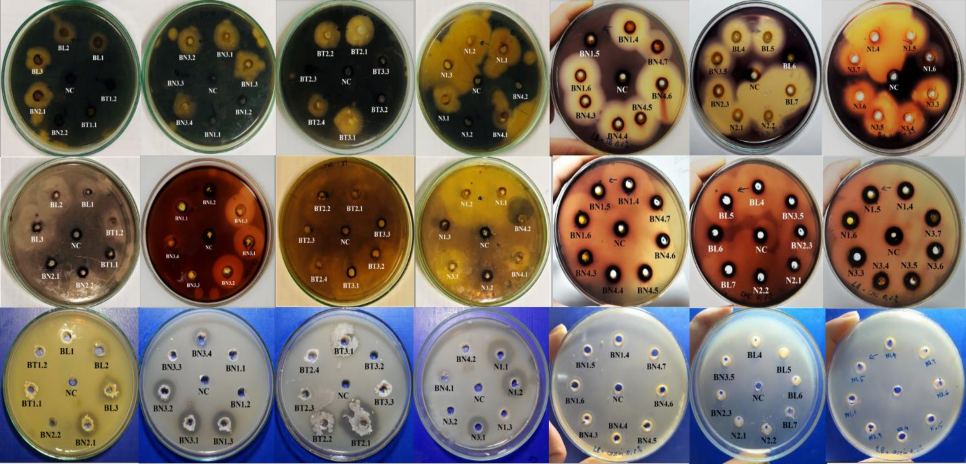
Hình 4 1 Khả năng sinh tổng hợp enzyme amylase cellulase và protease 34 Khả năng 1
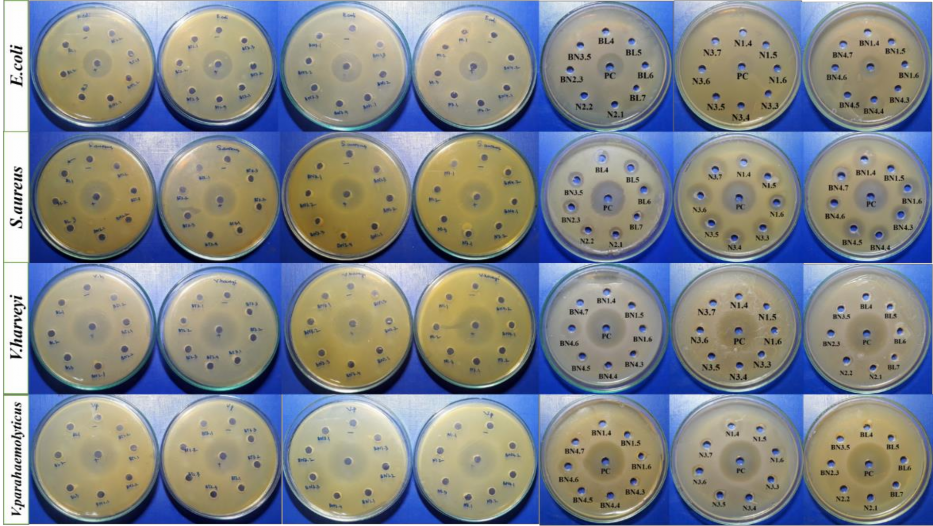
Hình 4 2 Khả năng kháng các chủng vi khuẩn kiểm định của các chủng vi 2

TO-BN3.5 | 13 | 25 | 6 | |
45 | TO-BN1.4 | 11 | 27 | 6 |
46 | TO-BN1.5 | - | - | - |
47 | TO-BN1.6 | 23 | 27 | 6 |
48 | TO-BN4.3 | 23 | 25 | 7 |
49 | TO-BN4.4 | 23 | 23 | 7 |
50 | TO-BN4.5 | 23 | 23 | 6 |
Có thể bạn quan tâm!
-
Tổng Quan Các Công Trình Nghiên Cứu, Sản Xuất Bacteriocin Trong Và Ngoài Nước -
Đối Tượng, Nội Dung Và Phương Pháp Nghiên Cứu -
Định Danh Chủng Vi Sinh Vật Có Khả Năng Sinh Tổng Hợp Bacteriocin Đã Được Tuyển Chọn -
Cây Phát Sinh Chủng Loại Của Chủng Vi Khuẩn Chọn Lọc N1.4 Với Các Trình Tự Gen Trên Genbank Có Mức Độ Tương Đồng Cao Nhất -
Phân lập và tuyển chọn chủng probiotic sinh tổng hợp bacteriocin từ ruột tôm nước mặn tỉnh Nam Định để ứng dụng trong sản xuất thức ăn chăn nuôi tôm - 8 -
Phân lập và tuyển chọn chủng probiotic sinh tổng hợp bacteriocin từ ruột tôm nước mặn tỉnh Nam Định để ứng dụng trong sản xuất thức ăn chăn nuôi tôm - 9
Xem toàn bộ 81 trang tài liệu này.
Phát triển các chế phẩm sinh học trong trong nuôi trồng thuỷ sản từ các loài vi sinh vật bản địa là hướng đi đúng đắn của các cơ sở nghiên cứu khoa học nhằm hướng đến mục tiêu giảm và dừng sử dụng hoá chất và kháng sinh. Trong số 50 khuẩn lạc thuần nghiên cứu, có 13/50 khuẩn lạc không có khả năng sinh enzyme ngoại bào hoặc có sinh enzyme nhưng rất yếu. 37 /50 khuẩn lạc có khả năng sinh từ 2 đến 3 loại enzyme kiểm định. Trong đó chủng N1.4 cho khả năng sinh 2 enzyme amylase, cellulase cao nhất và hoạt tính protease khá cao. Chủng này được chọn lọc để nghiên cứu tiếp.
Khả năng sinh tổng hợp 3 loại enzyme amylase, cellulase và protease trên môi trường có bổ sung cơ chất tương ứng lần lượt là tinh bột, CMC và casein được thể hiện trên hình 4.1.
Hình 4.1. Khả năng sinh tổng hợp enzyme amylase, cellulase và protease
34
Khả năng đối kháng với các vi khuẩn kiểm định
Khả năng kháng khuẩn của các chủng phân lập được từ ruột tôm được xác định dựa trên kích thước vòng ức chế đối với các vi sinh vật gây bệnh trên đĩa thạch (như mô tả phần phương pháp). Kết quả về khả năng kháng khuẩn của các chủng phân lập được trình bày trong bảng 4.3.
Bảng 4.3. Khả năng kháng khuẩn của các chủng phân lập được từ ruột tôm
Vòng ức chế của các vi sinh vật gây bệnh (mm) | |||||
TT | Tên | E.coli | S.aureus | V.harveyi | V. parahaemolyticus |
ĐC* | 13 | 19 | 23 | 23 | |
1 | TO-N1.1 | - | - | - | - |
2 | TO-N1.2 | - | - | - | - |
3 | TO-N1.3 | - | - | - | - |
4 | TO-N3.1 | - | - | - | - |
5 | TO-N3.2 | - | - | - | - |
6 | TO-BN1.1 | - | - | - | - |
7 | TO-BN1.2 | - | - | - | - |
8 | TO-BN1.3 | - | - | - | - |
9 | TO-BN2.1 | - | - | - | - |
10 | TO-BN2.2 | - | - | - | - |
11 | TO-BN3.1 | - | - | - | - |
12 | TO-BN3.2 | - | - | - | - |
13 | TO-BN3.3 | - | - | - | - |
14 | TO-BN3.4 | - | - | - | - |
15 | TO-BN4.1 | - | - | - | - |
16 | TO-BN4.2 | - | - | - | - |
17 | TO-BT1.1 | - | - | - | - |
18 | TO-BT1.2 | - | - | - | - |
TO-BT2.1 | - | - | - | - | |
20 | TO-BT2.2 | - | - | - | - |
21 | TO-BT2.3 | - | - | - | - |
22 | TO-BT2.4 | - | - | - | - |
23 | TO-BT3.1 | - | - | - | - |
24 | TO-BT3.2 | - | - | - | - |
25 | TO-BT3.3 | - | - | - | - |
26 | BL1 | - | - | - | - |
27 | BL2 | - | - | - | - |
28 | BL3 | - | - | - | - |
29 | N1.4 | - | 12 | 11 | 12 |
30 | TO-N1.5 | - | 12 | - | 2 |
31 | TO-N1.6 | - | 5 | - | - |
32 | TO-N3.3 | - | 9 | - | - |
33 | TO-N3.4 | - | 9 | - | 2 |
34 | TO-N3.5 | - | 10 | - | 2 |
35 | TO-N3.6 | - | 10 | - | 1 |
36 | TO-N3.7 | - | 11 | - | 2 |
37 | BL4 | - | 5 | - | - |
38 | BL5 | - | 5 | - | - |
39 | BL6 | - | + | - | - |
40 | BL7 | - | + | - | - |
41 | TO-N2.1 | - | 2 | - | - |
42 | TO-N2.2 | - | 3 | - | - |
43 | TO-BN2.3 | - | 5 | - | - |
44 | TO-BN3.5 | - | 5 | - | - |
45 | TO-BN1.4 | - | 11 | - | - |
46 | TO-BN1.5 | - | - | - | - |
TO-BN1.6 | - | 10 | - | + | |
48 | TO-BN4.3 | - | 8 | - | + |
49 | TO-BN4.4 | - | 9 | + | - |
50 | TO-BN4.5 | - | 9 | 2 | + |
*ĐC - đối chứng, 30 µl dung dịch khánh sinh streptomycin (0,1 g/L)
Kết quả nghiên cứu ở bảng 4.3 cho thấy 31/50 chủng không có khả năng kháng khuẩn.
Kết quả cho thấy 19/50 chủng phân lập cho khả năng kháng khuẩn từ 1 đến 3 chủng vi khuẩn kiểm định. Không có chủng nào cho khả năng kháng cả 4 chủng vi khuẩn kiểm định. Trong số các chủng có khả năng kháng khuẩn, chủng N1.4 cho khả năng kháng 3 vi khuẩn kiểm định (S.aureus, V.harveyi, V. parahaemolyticus) với kích thước vòng kháng khuẩn lần lượt là 12, 11 và 12 mm. Không có chủng vi khuẩn phân lập nào cho khả năng kháng vi khuẩn E.coli
Khả năng kháng các chủng vi khuẩn kiểm định gây bệnh đường ruột động vật (E.coli, S.aureus, V.harveyi, V. parahaemolyticus) của các chủng phân lập được trên môi trường LB thạch, ủ 37ᵒC, 24 giờ được thể hiện trên hình 4.2.
Hình 4.2. Khả năng kháng các chủng vi khuẩn kiểm định của các chủng vi khuẩn phân lập từ ruột tôm.
38
Trong nghiên cứu này, từ các chủng phân lập từ ruột tôm cho thấy, 13/50 chủng không sinh tổng hợp các loại enzyme amylase, cellulase và protease, các chủng còn lại có khả năng sinh tổng hợp ít nhất 1 trong 3 loại enzyme trên.
Trong đó, có 37/50 chủng có khả năng sinh tổng hợp 3 loại enzyme này.
Chủng N1.4 sinh tổng hợp 2 loại amylase và cellulase rất mạnh, hoạt tính protease yếu hơn nhưng cũng rất tiềm năng. Hầu hết các chủng đều không có khả năng kháng hoặc kháng yếu 2 chủng vi khuẩn kiểm định là E.coli, Vibrio harveyi.
Có 7/50 chủng có khả năng ức chế Vibrio parahaemolyticus và 21/50 chủng có khả năng kháng S.aureus.
Từ các kết quả phân tích về hoạt tính sinh tổng hợp enzyme thủy phân, cũng như khả năng kháng vi khuẩn kiểm định, chủng N1.4 thể hiện tiềm năng cả về sinh enzyme thủy phân và khả năng sinh chất bacteriocin cao hơn các chủng phân lập còn lại. Do đó, chủng N1.4 được tuyển chọn, định danh và nghiên cứu tiếp.
4.2. Định danh đến loài chủng vi sinh vật được tuyển chọn
DNA tổng số của chủng N1.4 được tách và tinh sạch được sử dụng để nhân đoạn gen trên 16S-RNA. Trình tự 16S-r RNA được xác định và trình bày trên hình 4.3.

Hình 4.3. Trình tự đoạn gen của rARN 16S của chủng vi khuẩn chọn lọc N1.4 Từ đoạn trình tự được giải mã của chủng N1.4 trên, tiến hành tìm kiếm
những trình tự nucleotide của các chủng tương đồng với trình tự của chủng N1.4 trên website http://www.ncbi.nlm.nih.gov/ để xây dựng cây phân loại, nhằm so sánh và tìm ra nguồn gốc của chủng chọn lọc N1.4. Cây phân loại được lập dựa vào phần mềm là Mega và FlinchTV.
Sự tương đồng về trình tự nucleotide của N1.4 và 13 trình tự nucleotide được tải về từ Genbank ( http://www.ncbi.nlm.nih.gov/) và mối quan hệ về mặt nguồn gốc phát sinh của N1.4 với 13 chủng vi khuẩn đó được thể hiện trong hình
4.4 như sau:






